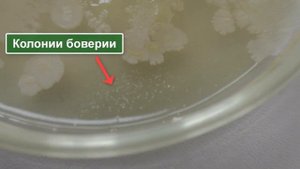

4:20
4:20
2024-11-06 07:06

 11:29
11:29

 11:29
11:29
2023-11-24 12:45

 5:28
5:28

 5:28
5:28
2023-12-28 00:22

 24:31
24:31

 24:31
24:31
2025-05-20 04:47

 37:27
37:27

 37:27
37:27
2024-02-02 04:34

 7:04
7:04

 7:04
7:04
2024-08-09 18:05

 38:53
38:53

 38:53
38:53
2024-04-08 12:54

 3:10
3:10

 3:10
3:10
2024-01-17 19:51

 1:09
1:09

 1:09
1:09
2025-05-28 14:00

 24:34
24:34

 24:34
24:34
2025-05-03 00:05

 33:53
33:53

 33:53
33:53
2025-09-14 06:00

 1:36:41
1:36:41

 1:36:41
1:36:41
2023-08-22 10:39

 1:25
1:25

 1:25
1:25
2023-08-10 12:01

 4:00
4:00

 4:00
4:00
2023-08-27 17:04

 2:14
2:14
2:14
2:14
2023-08-25 09:51

 2:34
2:34

 2:34
2:34
2023-09-15 10:15

 1:16
1:16

 1:16
1:16
2022-10-02 09:00

 2:50
2:50
![Премьера клипа! AY YOLA - Ugez]() 3:53
3:53
![Премьера клипа! ANIVAR - ТАК И НЕ ПОНЯЛ]() 2:37
2:37
![Премьера клипа! Артур Бесаев - Просто знай]() 2:44
2:44
![Премьера! Джиган и NILETTO ft. Loc-Dog - Дорого (LIVE)]() 2:37
2:37
![Премьера клипа! Моя Мишель и Баста - Не поняла]() 3:22
3:22
![Премьера клипа! Лизогуб и Amirchik - Неуловимая]() 2:26
2:26
![Премьера клипа! Roza Zergerli - Одинокая]() 2:22
2:22
![Премьера клипа! NEMIGA, NAVAI - Пойдем в кино]() 2:47
2:47
![Премьера клипа! Егор Крид - Одиноко]() 2:16
2:16
![Премьера клипа! Ани Лорак — Такси]() 3:22
3:22
![Премьера клипа! Ленинград — Бешеный фэшн]() 2:52
2:52
![Премьера! 3-ий Январь и IL'GIZ - Дорога дальняя]() 2:44
2:44
![DJ БлокNote - Ночь, Улица, фонарь, Аптека]() 2:09
2:09
![Премьера клипа! Zivert – Гудбай]() 4:20
4:20
![Премьера клипа! Анастасия Сотникова - Первая любовь]() 2:37
2:37
![Миша Хорев - Лилии]() 3:02
3:02
![Премьера клипа! Инна Вальтер - Верная]() 3:44
3:44
![Премьера клипа! Дима Билан - Что то на родном]() 3:38
3:38
![Премьера клипа! ХАБИБ - Шаганэ]() 2:49
2:49
![Премьера клипа! Инна Вальтер - С козырей зашёл]() 3:31
3:31
![Финикийская схема (2025)]() 1:41:00
1:41:00
![Порочный круг | Vicious (2025)]() 1:42:30
1:42:30
![Рыжая Соня (2025)]() 1:50:40
1:50:40
![Добыча (2022)]() 1:45:08
1:45:08
![Стив | Steve (2025)]() 1:33:34
1:33:34
![Хищник | Predator (1987) (Гоблин)]() 1:46:40
1:46:40
![Девушка из каюты №10 | The Woman in Cabin 10 (2025)]() 1:35:11
1:35:11
![Последний клиент]() 1:33:23
1:33:23
![Чумовая пятница (2003)]() 1:36:57
1:36:57
![Терминатор 2: Судный день | Terminator 2: Judgment Day (1991) (Гоблин)]() 2:36:13
2:36:13
![Некая справедливость (2014)]() 1:32:52
1:32:52
![Школьный автобус (2025)]() 2:09:51
2:09:51
![Первый день моей жизни]() 1:56:45
1:56:45
![История моей жены]() 2:42:50
2:42:50
![Облако (2024)]() 2:04:02
2:04:02
![Алиса в Стране чудес: Все части 1, 2 (фильмы)]() 4:14:09
4:14:09
![Монстры: История Эда Гейна (2025) (мини-сериал)]() 7:26:60
7:26:60
![Комната (2003)]() 1:39:52
1:39:52
![Пойман с поличным (2025)]() 1:46:41
1:46:41
![Терминатор | The Terminator (1984) (Гоблин)]() 1:47:17
1:47:17
![Земля до начала времён 4: Путешествие в Землю Туманов (1996) / The Land Before Time IV]()
 1:13:52
1:13:52
![Плохие парни: Очень плохой праздник (2023) / The Bad Guys: A Very Bad Holiday]()
 22:30
22:30
![Ночная жуть Тайни Тун (1995) / Tiny Toon Night Ghoulery]()
 43:38
43:38
![Земля до начала времён 13: Сила дружбы (2007) / The Land Before Time XIII]()
 1:15:39
1:15:39
![Дорога домой (2021) / Back to the Outback]()
 1:31:40
1:31:40
![Барби: Скиппер и большое приключение с детьми (2023) / Skipper and the Big Babysitting Adventure]()
 1:02:58
1:02:58
![Альфа и Омега 5: Семейные каникулы (2014) / Alpha and Omega: Family Vacation]()
 43:30
43:30
![Земля до начала времён 6: Тайна Скалы Динозавров (1998) / The Land Before Time VI]()
 1:12:60
1:12:60
![Альфа и Омега 3: Большие Волчьи Игры (2013) / Alpha and Omega 3: The Great Wolf Games]()
 45:01
45:01
![Плохие парни 2 (2025) / The Bad Guys 2]()
 1:43:47
1:43:47
![Девочки из Эквестрии. Легенды вечнозелёного леса (2016) / Equestria Girls. Legend of Everfree]()
 1:13:14
1:13:14
![Земля до начала времён 2: Приключения в Великой Долине (1994) / The Land Before Time II]()
 1:13:31
1:13:31
![Земля до начала времён 5: Таинственный остров (1997) / The Land Before Time V]()
 1:13:30
1:13:30
![Смурфики (2011) / The Smurfs]()
 1:42:44
1:42:44
![Земля до начала времён 10: Великая миграция (2003) / The Land Before Time X]()
 1:24:21
1:24:21
![Шерлок Гномс (2018) / Sherlock Gnomes]()
 1:26:19
1:26:19
![Волшебный парк Джун (2019) / Wonder Park]()
 1:25:17
1:25:17
![Земля до начала времён 8: Великая стужа (2001) / The Land Before Time VIII]()
 1:15:49
1:15:49
![Смурфики в кино (2025) / Smurfs]()
 1:29:33
1:29:33
![Науэль и волшебная книга (2020) / Nauel and the Magic Book]()
 1:37:06
1:37:06

 2:50
2:50Скачать видео
| 256x144 | ||
| 640x360 | ||
| 1280x720 | ||
| 1920x1080 |
 3:53
3:53
2025-09-06 15:26
 2:37
2:37
2025-09-07 15:55
 2:44
2:44
2025-08-15 12:11
 2:37
2:37
2025-09-17 08:58
 3:22
3:22
2025-08-27 12:34
 2:26
2:26
2025-08-05 17:07
 2:22
2:22
2025-09-28 17:46
 2:47
2:47
2025-10-10 09:59
 2:16
2:16
2025-08-25 16:04
 3:22
3:22
2025-08-24 08:24
 2:52
2:52
2025-09-06 13:15
 2:44
2:44
2025-08-26 15:20
 2:09
2:09
2025-08-16 22:41
2025-08-29 15:43
 2:37
2:37
2025-09-02 11:35
2025-10-02 12:16
 3:44
3:44
2025-08-21 09:21
 3:38
3:38
2025-09-22 14:44
 2:49
2:49
2025-10-10 09:59
2025-09-30 09:56
0/0
 1:41:00
1:41:00
2025-10-05 21:22
 1:42:30
1:42:30
2025-10-14 20:27
 1:50:40
1:50:40
2025-10-15 14:11
 1:45:08
1:45:08
2025-10-06 12:51
 1:33:34
1:33:34
2025-10-08 12:27
 1:46:40
1:46:40
2025-10-07 09:27
 1:35:11
1:35:11
2025-10-13 12:06
 1:33:23
1:33:23
2025-10-13 11:36
 1:36:57
1:36:57
2025-10-05 17:21
 2:36:13
2:36:13
2025-10-07 09:27
2025-10-13 04:45
 2:09:51
2:09:51
2025-10-04 10:38
 1:56:45
1:56:45
2025-10-13 11:38
 2:42:50
2:42:50
2025-10-13 11:40
 2:04:02
2:04:02
2025-10-12 13:06
 4:14:09
4:14:09
2025-10-06 16:06
 7:26:60
7:26:60
2025-10-05 20:29
 1:39:52
1:39:52
2025-10-08 18:11
 1:46:41
1:46:41
2025-10-04 09:54
 1:47:17
1:47:17
2025-10-07 09:28
0/0

 1:13:52
1:13:52
2025-09-17 18:00

 22:30
22:30
2025-09-19 18:00

 43:38
43:38
2025-09-09 18:00

 1:15:39
1:15:39
2025-10-06 18:00

 1:31:40
1:31:40
2025-09-12 18:00

 1:02:58
1:02:58
2025-09-07 18:00

 43:30
43:30
2025-10-14 18:00

 1:12:60
1:12:60
2025-09-22 18:01

 45:01
45:01
2025-10-10 18:00

 1:43:47
1:43:47
2025-09-23 18:00

 1:13:14
1:13:14
2025-10-01 18:00

 1:13:31
1:13:31
2025-09-13 18:00

 1:13:30
1:13:30
2025-09-20 18:00

 1:42:44
1:42:44
2025-09-27 18:00

 1:24:21
1:24:21
2025-09-30 18:00

 1:26:19
1:26:19
2025-09-25 18:00

 1:25:17
1:25:17
2025-09-08 18:00

 1:15:49
1:15:49
2025-09-26 18:00

 1:29:33
1:29:33
2025-09-29 18:00

 1:37:06
1:37:06
2025-10-05 18:00
0/0

